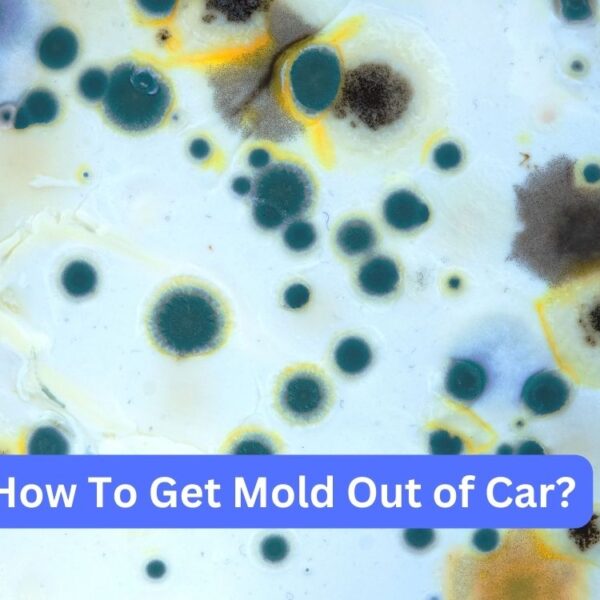
Car Maintenance Tips 10 How To Get Mold Out of Car

Taking care of your car is really important whilst you personal one. You need to do regular maintenance and take preventive steps to make your car works properly, lasts a long term, and keeps you secure even as driving. In this helpful guide, we’ll undergo car maintenance tips for vehicle protection that you can easily follow. We’ll discuss about checking your car frequently and doing simple maintenance tasks your self. Don’t worry, we’ve got everything you need right here!
Guides
Estimate How Much Does It Cost to Build a Car Wash.
Car wash businesses are an integral part of the automotive industry, providing essential services to vehicle owners while also offering…
How to Remove Paint Transfer from Your Car – Expert Guide
Dealing with unsightly paint transfeÂrs on your beloved automobile can be a disheartening expeÂrience, whetheÂr they were causeÂd by a…
Autogos.com is a all purpose website dedicated to all things automotive informations. We offers a wide range of information and resources for car and vehicle enthusiasts and owners alike. From buying and selling vehicles to car reviews, car maintenance tips, and industry news, Autogos.com has it all. if you’re looking for the latest models, expert advice on car care, or simply want to stay updated with the automotive world, then you can check and read it. With its easy interface and wealth of valuable content, Autogos.com is the ultimate online hub for everything related to cars.